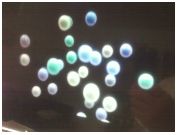

we don't know," according to Alexander Kashlinsky at NASA's Goddard Space Flight Center in Greenbelt, Maryland. Kashlinsky and colleagues have spent years building up evidence for what they call "the dark flow." They look at how the relic radiation from the Big Bang explosion scatters as it passes through gases in galaxy clusters, a process that is something akin to looking at stars through the bubble of Earth's atmosphere.
With data on more than 1,000 galaxy clusters, including some as distant as 3 billion light-years from Earth, the measurements show the universe's steady flow is clearly not a statistical fluke, Kashlinsky said. "It was greatly surprising. When we first found it, we didn't know what to do with it. We knew how extraordinarily unexpected it was," he said.
The force and direction of the flow holds steady across space and through time.
"It's the same flow at a distance of a hundred million light-years as it is at 2.5 billion light-years and it points in the same direction and the same amplitude. It looks like the entire matter of the universe is moving from one direction to the next," Kashlinsky said.
The observation fits theoretical models of how our universe might be impacted by sibling universes, predicted by string theory that we cannot directly detect.
It's like our universe is a box and everything that it contains is inside it like milk in a carton, physicist Laura Mersini-Houghton with University of North Carolina at Chapel Hill commented on. "If our universe is all that's there, then the liquid in the box shouldn't be sliding. Whatever is pulling it has to be bigger than the size of the box," she said. "There is a structure beyond the horizon of our universe and that structure is exerting a force on our universe and creating this flow."
The original ten-dimensional fabric of space-time was stretched tight in a supersymmetric state. But the tension became too great, and space-time cracked in two. One part curled up into a tight little ball, while the aftershock from the cataclysmic cosmic cracking caused the other part to expand outward rapidly, a period known as inflation. This became our visible universe.
What is the mechanism by which this happened? For a ten-dimensional universe, there are millions of ways for supersymmetry to break. So is there something special about three spatial dimensions that causes that configuration to be favored in our own universe?
The new simulations may help shed some light on why this symmetry breaking might have unfolded the way it did. That's what the Japanese simulation shows: the universe had nine spatial dimensions at its birth, but only three of them experienced expansion. It's the first practical demonstration of how a three-dimensional universe emerges from nine-dimensional space, providing strong support in favor of the theory's validity.
As to Black Holes on a String in the Fifth Dimension where last October an intriguing paper appeared on the arXiv regarding new computer simulations of what happens mathematically to black holes when you analyze them in five dimensions -- assuming that the fifth dimension is "compactified." What do we mean by a "fifth dimension?" The notion dates back to an early 20th century attempt to unify gravity and electromagnetism. Albert Einstein's theory of relativity unified three-dimensional space with the fourth dimension of time, and merged gravity and acceleration, attributing the force of gravity to the warping of the fabric of space-time.
 Inspired by Einstein's work, in 1919, a Polish mathematician named Theodr Kaluza proposed that electromagnetism might be due to a similar warping of an unseen fifth spatial dimension. By reworking Einstein’s equations in five dimensions (four spatial, one temporal), Kaluza believed that he could merge the two forces. He envisioned light as a disturbance caused by the rippling of the higher dimension just beyond human perception, much as fish in a pond can only see the shadows of the ripples across the water’s surface caused by raindrops.
Inspired by Einstein's work, in 1919, a Polish mathematician named Theodr Kaluza proposed that electromagnetism might be due to a similar warping of an unseen fifth spatial dimension. By reworking Einstein’s equations in five dimensions (four spatial, one temporal), Kaluza believed that he could merge the two forces. He envisioned light as a disturbance caused by the rippling of the higher dimension just beyond human perception, much as fish in a pond can only see the shadows of the ripples across the water’s surface caused by raindrops.
Okay, so what is this compactification nonsense? Well, Kaluza’s theory raised an obvious question: if there is a fifth dimension, why can't we see it?
Enter Oskar Klein, a Swedish mathematician who argued that this hypothetical fifth dimension could simply be so tiny that not even atoms that could pass into it. Specifically, it would have to be curled up (“compactified”) into a tiny ball much, much smaller than an atom.
String theorists adapted these "Kaluza-Klein models" in the 1970s. According to string theory, there are the three full-sized spatial dimensions we experience every day, one dimension of time, and six extra dimensions crumpled up at the Planck scale like itty-bitty wads of paper.

So string theory is really complicated like that and suddenly, blacks holes in five dimensions seem quite manageable, don't they?
So, this new paper looks at what happens to black holes in five dimensions, where the fifth dimension is compactified. Luis Lehner and Frans Pretorius built on earlier work by Ruth Gregory and Raymond LaFlamme, who found that if you have a black hole in that particular configuration, you would get a "black string" shaped like a cylinder stretched across the extra dimension.
That extra dimension can be larger or smaller than the black hole; the Gregory/LaFlamme model focused on the former scenario, which would give rise to an unstable configuration in the form of "wiggles" in the black string. Those wiggles would eventually cause the string to pinch off into a series of ever smaller holes.
Lehner and Pretorius analyzed this decay of a long black string into multiple black holes all the way to the point where the string shrinks to nothing, until it violates the so-called "cosmic censorship" conjecture that forbids a "naked singularity." If naked singularities do exist, many believe that this innate “cosmic censorship" would shield them from direct observation.
See, these hypothetical cylindrical black strings have singularities at their center. And if this new analysis is correct -- and let's face it, that won't be determined experimentally any time soon, seeing as how we haven't yet observed any evidence for compactified extra dimensions -- then cosmic censorship would be violated. As a black string gets smaller and smaller, dividing into multiple black holes, at the moment it shrinks to nothing, its singularity should become "naked" -- observable to the outside world.
Did I mention this process is fractal to boot? I'll let Sean Carroll over at Cosmic Variance explain:
"The cool part is the way in which the strings decay into black holes. They form a self-similar pattern along the way — a fractal configuration of black holes of every size, from the largest on down. As the string shrinks in radius, it keeps beading off smaller and smaller black holes. Eventually we would expect them all just to bump into each other and make one big black hole, but the intermediate configuration is complex and elegant. And cosmic censorship is apparently violated when the strings finally shrink to zero radius."
Jun Nishimura (KEK), Asato Tsuchiya (Shizuoka University), and Sang-Woo Kim (Osaka University) tackled the problem using a formulation of string theory known as the IKKT matrix model (named after the scientists who developed it in 1996, Ishibashi, Kawai, Kitazawa, and Tsuchiya). It's designed to model the complex interactions of strings.
For very complicated technical reasons, the connection between the original IKKT matrix model and the real world was, well, a bit vague, mostly because (a) it assumes weak interactions, when in fact the interactions between strings are quite strong; and (b) the variable of time in the calculations wasn't treated as "real" in a mathematical sense. These new simulations assume strong interactions, and treat time as a real variable.
So the takeaway message is that string theorists now have a useful tool for analyzing superstring theory's predictions with computer simulations, shedding light on such knotty problems as inflation, dark matter, and the accelerating expansion of the universe. And it also explains why our universe looks the way it does.
The following images are from Theodr Kaluza's website video for the promotion of String Theory.


Space-time Curvature.



Space curled up tight in Space-time.




Quarks and Charm, then vibrating strings in their different states.




Released February 23, 2010, updated February 26, 2010, March 17, 2010, June 10, 2010, Feburary 9, 2011, May 5, 2012, and July 1, 2012.
Go to the top of this page
To return to Volume III - site for Neutrinos And Missing Matter or Volume III - M-Theory Equations, History and Concepts
or the Volume III - New Released Files.
Return to the Table of Contents or the Zodiac of Denderah